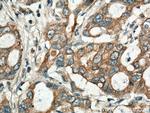
BEGAIN Antibody in Immunohistochemistry (Paraffin) (IHC (P))

Search
Proteintech
BEGAIN Polyclonal Antibody
{{$productOrderCtrl.translations['antibody.pdp.commerceCard.promotion.promotions']}}
{{$productOrderCtrl.translations['antibody.pdp.commerceCard.promotion.viewpromo']}}
{{$productOrderCtrl.translations['antibody.pdp.commerceCard.promotion.promocode']}}: {{promo.promoCode}} {{promo.promoTitle}} {{promo.promoDescription}}. {{$productOrderCtrl.translations['antibody.pdp.commerceCard.promotion.learnmore']}}
产品信息
14956-1-AP
种属反应
已发表种属
宿主/亚型
分类
类型
抗原
偶联物
形式
浓度
规格
纯化类型
保存液
内含物
保存条件
运输条件
产品详细信息
Immunogen sequence: DIYCSDTAL YCPEERRRDR RPSVDAPVTD VGFLRAQNST DSAAEEEEEA EAAAFPAGFQ HEAFPSYAGS LPTSSSYSSF SATSEEKEHA QASTLTASQQ AIYLNSRDEL FDRKPPATTY EGSPRFAKAT AAVAAPLEAE VAPGFGRTMS PYPAETFRFP ASPGPQQALM PPNLWSLRAK PGTARLPGED MRGQWRPLSV EDIGAYSYPV SAAGRASPCS FSERYYGGAG GSPGKKADGR ASPLYASYKA DSFSEGDDLS QGHLAEPCFL RAGGDLSLSP GRSADPLPGY APSEGGDGDR LGVQLCGTAS SPEPEQGSRD SLEPSSMEAS PEMHPAARLS PQQAFPRTGG SGLSRKDSLT KAQLYGTLLN (225-593 aa encoded by BC002607)
靶标信息
May sustain the structure of the postsynaptic density (PSD). Target protein binds the guanylate kinase domain of PSD-95/SAP90, may play a role in the post-synaptic membrane.
仅用于科研。不用于诊断过程。未经明确授权不得转售。
生物信息学
蛋白别名: brain-enriched guanylate kinase-associated homolog; Brain-enriched guanylate kinase-associated protein; brain-enriched guanylate kinase-associated; brain-enriched guanylate kinase-associated protein
基因别名: BEGAIN; BM948371; Gm897; KIAA1446
UniProt ID: (Human) Q9BUH8, (Mouse) Q68EF6
Entrez Gene ID: (Human) 57596, (Mouse) 380785